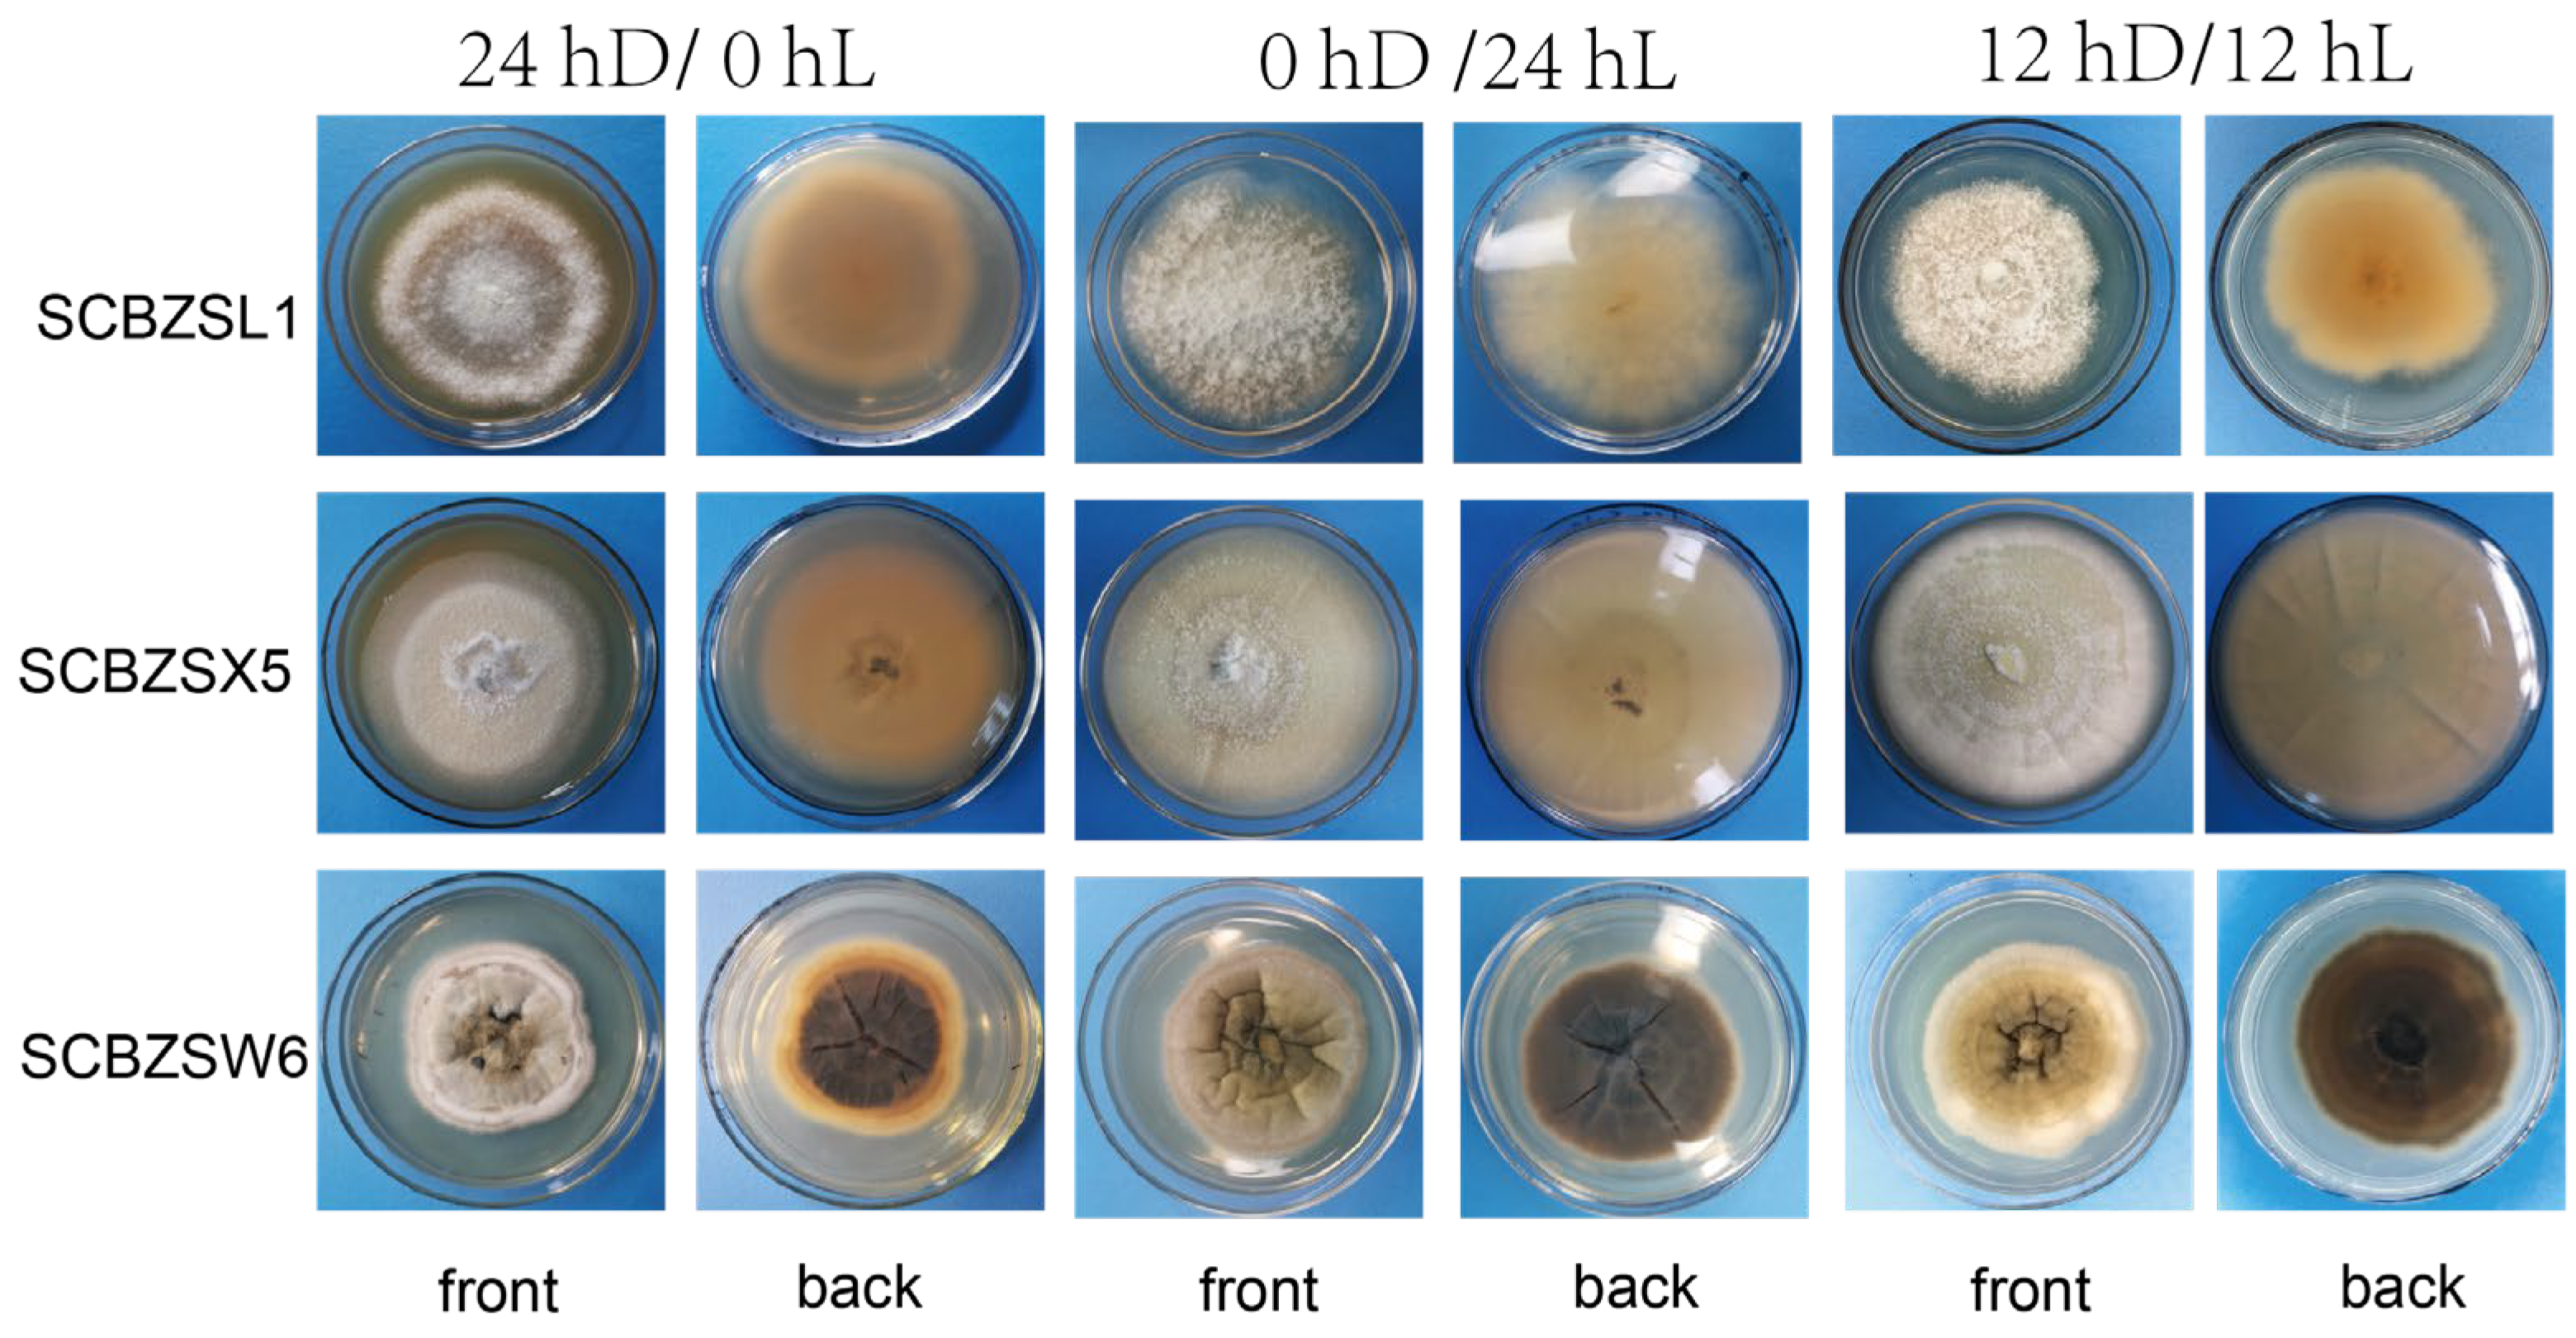
Plants 12 03091 g008

First Report of Fungal Pathogens Causing Leaf Spot on Sorghum–Sudangrass Hybrids and Their Interactions with Plants
Abstract
:1. Introduction
2. Results
2.1. Evaluation of the Pathogenicity of 3 Pathogenic Fungi
2.2. Morphological Identification
2.3. Phylogenetic Tree Analysis
2.4. Effect of Different Light on the Growth of the Test Strains
2.5. Effect of Different Temperatures on the Growth of the Test Strains
2.6. Effect of Different Media on the Growth of the Test Strains
2.7. Effect of pH on the Growth of the Test Strains
2.8. Effect of Pathogenic Fungi on Plant Metabolism
3. Discussion
4. Materials and Methods
4.1. Sample Collection and Fungal Isolation
4.2. Pathogenicity Test
4.3. Morphological Identification
4.4. Molecular Identification and Phylogentic Analysis
4.5. Effect of Photoperiod on the Growth of the Test Strains
4.6. Effect of Temperature on the Growth of the Test Strains
4.7. Effect of Different Media on the Growth of the Test Strains
4.8. Effect of pH on the Growth of the Test Strains
4.9. Induced Spore Production Test
4.10. Metabolomics Analysis
4.11. Statistical Analysis
5. Conclusions
Author Contributions
Funding
Data Availability Statement
Acknowledgments
Conflicts of Interest
References
- Lu, Q.; Yu, X.; Wang, H.; Yu, Z.; Zhang, X.; Zhao, Y. Quantitative Trait Locus Mapping for Important Yield Traits of a sorghum-sudangrass hybrid Using a High-Density Single Nucleotide Polymorphism Map. Front. Plant Sci. 2022, 13, 1098605. [Google Scholar] [CrossRef]
- Choi, N.; Kim, G.; Park, W.; Jeong, Y.; Kim, Y.; Na, C.-I. Additional N Application and Ecotype Affect Yield and Quality of Ratoon Harvested Sorghum x Sudangrass Hybrid for Temperate Regions. Biomass Bioenergy 2022, 160, 106423. [Google Scholar] [CrossRef]
- Kaplan, M.; Kara, K.; Unlukara, A.; Kale, H.; Buyukkilic Beyzi, S.; Varol, I.S.; Kizilsimsek, M.; Kamalak, A. Water Deficit and Nitrogen Affects Yield and Feed Value of Sorghum Sudangrass Silage. Agric. Water Manag. 2019, 218, 30–36. [Google Scholar] [CrossRef]
- Peng, J.; Kim, M.; Sung, K. Yield Prediction Modeling for Sorghum–Sudangrass Hybrid Based on Climatic, Soil, and Cultivar Data in the Republic of Korea. Agriculture 2020, 10, 137. [Google Scholar] [CrossRef]
- Lu, Q.; Yu, X.; Wang, H.; Yu, Z.; Zhang, X.; Zhao, Y. Construction of Ultra-High-Density Genetic Linkage Map of a sorghum-sudangrass hybrid Using Whole Genome Resequencing. PLoS ONE 2022, 17, e0278153. [Google Scholar] [CrossRef]
- Alabi, O.J.; Al Rwahnih, M.; Isakeit, T.; Gregg, L.; Jifon, J.L. First Report of Rottboellia Yellow Mottle Virus Infecting Sorghum Sudangrass Hybrid (Sorghum bicolor × Sorghum bicolor Var. sudanense) in North America. Plant Dis. 2016, 100, 1255. [Google Scholar] [CrossRef]
- Li, T.; Tang, H. An analysis of the control of pests and diseases and processing and utilisation of Sorghum sudangrass hybird. China Acad. J. Electron. Publ. House 2018, 14, 36–37. [Google Scholar]
- Zhu, Y. A Method and Process for Isolation and Identification of Pathogen of Sorghum bicolor Leaf Spot Disease 2016. National Intellectual Property Office Homepage. Available online: https://www.cnipa.gov.cn (accessed on 24 April 2023).
- Duan, D.; Feng, X.; Wu, N.; Tian, Z.; Dong, X.; Liu, H.; Nan, Z.; Chen, T. Drought Eliminates the Difference in Root Trait Plasticity and Mycorrhizal Responsiveness of Two Semiarid Grassland Species with Contrasting Root System. Int. J. Mol. Sci. 2023, 24, 10262. [Google Scholar] [CrossRef] [PubMed]
- Wang, M.; Liu, F.; Crous, P.W.; Cai, L. Phylogenetic Reassessment of Nigrospora: Ubiquitous Endophytes, Plant and Human Pathogens. Persoonia 2017, 39, 118–142. [Google Scholar] [CrossRef]
- Damm, U.; Sato, T.; Alizadeh, A.; Groenewald, J.Z.; Crous, P.W. The Colletotrichum Dracaenophilum, C. magnum and C. orchidearum Species Complexes. Stud. Mycol. 2019, 92, 1–46. [Google Scholar] [CrossRef]
- Scarpari, M.; Vitale, S.; Di Giambattista, G.; Luongo, L.; De Gregorio, T.; Schreiber, G.; Petrucci, M.; Belisario, A.; Voglmayr, H. Didymella corylicola Sp. Nov., a New Fungus Associated with Hazelnut Fruit Development in Italy. Mycol. Prog. 2020, 19, 317–328. [Google Scholar] [CrossRef]
- Xun, W.; Gong, B.; Liu, X.; Yang, X.; Zhou, X.; Jin, L. Antifungal Mechanism of Phenazine-1-Carboxylic Acid against Pestalotiopsis Kenyana. Int. J. Mol. Sci. 2023, 24, 11274. [Google Scholar] [CrossRef]
- Hu, H.; Li, H.; Liao, F.; Wang, L. Study on the classification of Colletotrichum gloeosporioides of various economic crops in Fujian. In Proceedings of the 2016 Annual Academic Conference of the Chinese Society of Fung, Fuzhou, China, 19 August 2016; p. 192. [Google Scholar]
- Silva-Rojas, H.V.; Ávila-Quezada, G.D. Phylogenetic and Morphological Identification of Colletotrichum Boninense: A Novel Causal Agent of Anthracnose in Avocado. Plant Pathol. 2011, 60, 899–908. [Google Scholar] [CrossRef]
- Cabrera, L. Most Colletotrichum Species Associated with Tree Tomato (Solanum betaceum) and Mango (Mangifera indica) Crops Are Not Host-Specific. BSPP 2018, 67, 1022–1030. [Google Scholar] [CrossRef]
- Chung, P.-C.; Wu, H.-Y.; Wang, Y.-W.; Ariyawansa, H.A.; Hu, H.-P.; Hung, T.-H.; Tzean, S.-S.; Chung, C.-L. Diversity and Pathogenicity of Colletotrichum Species Causing Strawberry Anthracnose in Taiwan and Description of a New Species, Colletotrichum miaoliense sp. nov. Sci. Rep. 2020, 10, 14664. [Google Scholar] [CrossRef] [PubMed]
- Li, D. Study on Pathogen Identification and Biological Characteristics of Fig Anthracnose and Screening of Effective Fungicides. Master’s Thesis, Anhui Agricultural University, Hefei, China, 2019. [Google Scholar]
- Chen, X. Study on Identification and Control of Pathogens of Bodhi Tree Anthracnose. Master’s Thesis, Guangxi University, Nanning, China, 2018. [Google Scholar]
- Zhao, Q. Studies on Colletotrichum gloeosporioides of Houttuynia cordata. Master’s Thesis, Sichuan Agricultural University, Ya’an, China, 2010. [Google Scholar]
- Zhang, H.; Lu, L.; Zhao, X.; Zhao, S.; Gu, X.; Du, W.; Wei, H.; Ji, R.; Zhao, L. Metabolomics Reveals the “Invisible” Responses of Spinach Plants Exposed to CeO2 Nanoparticles. Environ. Sci. Technol. 2019, 53, 6007–6017. [Google Scholar] [CrossRef]
- Xiong, J.-L.; Wang, H.-C.; Tan, X.-Y.; Zhang, C.-L.; Naeem, M.S. 5-Aminolevulinic Acid Improves Salt Tolerance Mediated by Regulation of Tetrapyrrole and Proline Metabolism in Brassica napus L. Seedlings under NaCl Stress. Plant Physiol. Biochem. 2018, 124, 88–99. [Google Scholar] [CrossRef]
- Li, Q.; Wang, J.; Bai, T.; Zhang, M.; Jia, Y.; Shen, D.; Zhang, M.; Dou, D. A Phytophthora Capsici Effector Suppresses Plant Immunity via Interaction with EDS1. Mol. Plant Pathol. 2020, 21, 502–511. [Google Scholar] [CrossRef]
- Shankar, A.; Agrawal, N.; Sharma, M.; Pandey, A.; Pandey, G.K. Role of Protein Tyrosine Phosphatases in Plants. Curr. Genom. 2015, 16, 224–236. [Google Scholar] [CrossRef]
- Liu, W.-C.; Song, R.-F.; Zheng, S.-Q.; Li, T.-T.; Zhang, B.-L.; Gao, X.; Lu, Y.-T. Coordination of Plant Growth and Abiotic Stress Responses by Tryptophan Synthase β Subunit 1 through Modulation of Tryptophan and ABA Homeostasis in Arabidopsis. Mol. Plant 2022, 15, 973–990. [Google Scholar] [CrossRef]
- Kim, D.-R.; Jeon, C.-W.; Cho, G.; Thomashow, L.S.; Weller, D.M.; Paik, M.-J.; Lee, Y.B.; Kwak, Y.-S. Glutamic Acid Reshapes the Plant Microbiota to Protect Plants against Pathogens. Microbiome 2021, 9, 244. [Google Scholar] [CrossRef]
- Noman, A.; Liu, Z.; Aqeel, M.; Zainab, M.; Khan, M.I.; Hussain, A.; Ashraf, M.F.; Li, X.; Weng, Y.; He, S. Basic Leucine Zipper Domain Transcription Factors: The Vanguards in Plant Immunity. Biotechnol. Lett. 2017, 39, 1779–1791. [Google Scholar] [CrossRef]
- Kallscheuer, N.; Vogt, M.; Marienhagen, J. A Novel Synthetic Pathway Enables Microbial Production of Polyphenols Independent from the Endogenous Aromatic Amino Acid Metabolism. ACS Synth. Biol. 2017, 6, 410–415. [Google Scholar] [CrossRef]
- Qiao, F.; Zhang, K.; Zhou, L.; Qiu, Q.-S.; Chen, Z.; Lu, Y.; Wang, L.; Geng, G.; Xie, H. Analysis of Flavonoid Metabolism during Fruit Development of Lycium Chinense. J. Plant Physiol. 2022, 279, 153856. [Google Scholar] [CrossRef]
- Shimoda, K.; Hamada, H. Synthesis of β-Maltooligosaccharides of Glycitein and Daidzein and Their Anti-Oxidant and Anti-Allergic Activities. Molecules 2010, 15, 5153–5161. [Google Scholar] [CrossRef]
- Uchida, K.; Sawada, Y.; Ochiai, K.; Sato, M.; Inaba, J.; Hirai, M.Y. Identification of a Unique Type of Isoflavone O-Methyltransferase, GmIOMT1, Based on Multi-Omics Analysis of Soybean under Biotic Stress. Plant Cell Physiol. 2020, 61, 1974–1985. [Google Scholar] [CrossRef]
- Ozfidan-Konakci, C.; Yildiztugay, E.; Alp, F.N.; Kucukoduk, M.; Turkan, I. Naringenin Induces Tolerance to Salt/Osmotic Stress through the Regulation of Nitrogen Metabolism, Cellular Redox and ROS Scavenging Capacity in Bean Plants. Plant Physiol. Biochem. 2020, 157, 264–275. [Google Scholar] [CrossRef] [PubMed]
- Ivanov, M.; Kannan, A.; Stojković, D.S.; Glamočlija, J.; Calhelha, R.C.; Ferreira, I.C.F.R.; Sanglard, D.; Soković, M. Flavones, Flavonols, and Glycosylated Derivatives—Impact on Candida Albicans Growth and Virulence, Expression of CDR1 and ERG11, Cytotoxicity. Pharmaceuticals 2021, 14, 27. [Google Scholar] [CrossRef]
- Pan, L.; Li, X.; Jin, H.; Yang, X.; Qin, B. Antifungal Activity of Umbelliferone Derivatives: Synthesis and Structure-Activity Relationships. Microb. Pathog. 2017, 104, 110–115. [Google Scholar] [CrossRef] [PubMed]
- Zafar-ul-Hye, M.; Akbar, M.N.; Iftikhar, Y.; Abbas, M.; Zahid, A.; Fahad, S.; Datta, R.; Ali, M.; Elgorban, A.M.; Ansari, M.J.; et al. Rhizobacteria Inoculation and Caffeic Acid Alleviated Drought Stress in Lentil Plants. Sustainability 2021, 13, 9603. [Google Scholar] [CrossRef]
- Okazaki, Y.; Otsuki, H.; Narisawa, T.; Kobayashi, M.; Sawai, S.; Kamide, Y.; Kusano, M.; Aoki, T.; Hirai, M.Y.; Saito, K. A New Class of Plant Lipid Is Essential for Protection against Phosphorus Depletion. Nat. Commun. 2013, 4, 1510. [Google Scholar] [CrossRef] [PubMed]
- Siebers, M.; Brands, M.; Wewer, V.; Duan, Y.; Hölzl, G.; Dörmann, P. Lipids in Plant–Microbe Interactions. Biochim. Biophys. Acta (BBA)—Mol. Cell Biol. Lipids 2016, 1861, 1379–1395. [Google Scholar] [CrossRef] [PubMed]
- Rodas-Junco, B.A.; Racagni-Di-Palma, G.E.; Canul-Chan, M.; Usorach, J.; Hernández-Sotomayor, S.M.T. Link between Lipid Second Messengers, and Osmotic Stress in Plants. Int. J. Mol. Sci. 2021, 22, 2658. [Google Scholar] [CrossRef] [PubMed]
- Kameoka, H.; Tsutsui, I.; Saito, K.; Kikuchi, Y.; Handa, Y.; Ezawa, T.; Hayashi, H.; Kawaguchi, M.; Akiyama, K. Stimulation of Asymbiotic Sporulation in Arbuscular Mycorrhizal fungi by Fatty Acids. Nat. Microbiol. 2019, 4, 1654–1660. [Google Scholar] [CrossRef]
- Zhang, P.-J.; He, Y.-C.; Zhao, C.; Ye, Z.-H.; Yu, X.-P. Jasmonic Acid-Dependent Defenses Play a Key Role in Defending Tomato Against Bemisia Tabaci Nymphs, but Not Adults. Front. Plant Sci. 2018, 9, 1065. [Google Scholar] [CrossRef]
- Li, T.; Cofer, T.M.; Engelberth, M.J.; Engelberth, J. Defense Priming by Non-Jasmonate Producing Fatty Acids in Maize (Zea mays). Plant Signal. Behav. 2016, 11, e1243635. [Google Scholar] [CrossRef]
- Ghassemi-Golezani, K.; Farhangi-Abriz, S. Changes in Oil Accumulation and Fatty Acid Composition of Soybean Seeds under Salt Stress in Response to Salicylic Acid and Jasmonic Acid. Russ. J. Plant Physiol. 2018, 65, 229–236. [Google Scholar] [CrossRef]
- Tang, X.; Yangjing, G.; Zhuoma, G.; Guo, X.; Cao, P.; Yi, B.; Wang, W.; Ji, D.; Pasquali, M.; Baccelli, I.; et al. Biological Characterization and In Vitro Fungicide Screenings of a New Causal Agent of Wheat Fusarium Head Blight in Tibet, China. Front. Microbiol. 2022, 13, 941734. [Google Scholar] [CrossRef]
- Fan, R.; Xie, D.; Nie, M.; Long, Y.; Zhao, Z. Identification and First Report of Colletotrichum Fructicola Causing Fruit Rot on Zizyphus mauritiana in China. Plant Dis. 2022, 106, 2751. [Google Scholar] [CrossRef]
- Khoo, Y.W.; Tan, H.T.; Khaw, Y.S.; Li, S.-F.; Chong, K.P. First Report of Epicoccum Sorghinum Causing Leaf Spot on Basella alba in Malaysia. Plant Dis. 2023, 107, 939. [Google Scholar] [CrossRef]
- Hu, G.; Zhao, Z.; Yang, H. Optimization of growth and sporulation conditions of salt-tolerant Trichoderma atroviride TW320 and Trichoderma pseudokoningii TW1876. Shandong Sci. 2022, 35, 65–73. [Google Scholar]
- Zhang, C.; Ou, X.; Wang, J.; Wang, Z.; Du, W.; Zhao, J.; Han, Y. Antifungal Peptide P852 Controls Fusarium Wilt in Faba Bean (Viciafaba L.) by Promoting Antioxidant Defense and Isoquinoline Alkaloid, Betaine, and Arginine Biosyntheses. Antioxidants 2022, 11, 1767. [Google Scholar] [CrossRef] [PubMed]

| Group | Number of Rhizomes (Root) | Root Bulk Density (cm3) | Plant Height (cm) | Root Length (cm) |
|---|---|---|---|---|
| SCBZSL1 | 10.99 ± 0.56 b | 1.42 ± 0.58 b | 104.63 ± 0.34 a | 8.76 ± 0.75 a |
| SCBZSX5 | 8.19 ± 0.88 c | 1.21 ± 0.49 b | 84.29 ± 0.66 b | 6.37 ± 0.46 b |
| SCBZSW6 | 11.43 ± 0.64 a | 4.88 ± 0.54 a | 105.53 ± 0.49 a | 8.95 ± 0.38 a |
| Control | 12.89 ± 0.76 a | 4.97 ± 0.37 a | 113.57 ± 3.75 a | 9.33 ± 0.58 a |
| Species | Accession Numbers 1,2 | Host | Locality | GenBank Accession Numbers 3 | ||||
|---|---|---|---|---|---|---|---|---|
| ITS | TUB2 | ACT | LSU | |||||
| SCBZSL1 | N. aurantiaca | LC 7302 | Nelumbo sp. (leaf) | China | KX986064 | KY019465 | - | KX986098 |
| N. camelliae-sinensis | LC 2710 | Castanopsis sp. | China | KX985957 | KY019484 | - | - | |
| N. chinensis | LC 2696 | Lindera aggregata | China | KX985947 | KY019474 | - | - | |
| N. guilinensis | LC 7301 | Nelumbo sp. (stem) | China | KX986063 | KY019459 | - | - | |
| N. hainanensis | LC 6979 | Musa paradisiaca (leaf) | China | KX986079 | KY019586 | - | - | |
| N. lacticolonia | LC 3324 | Camellia sinensis | China | KX985978 | KY019458 | - | KX986105 | |
| N. musae | CBS 319.34 * | Musa paradisiaca (leaf) | Australia | KX986076 | KY019455 | - | - | |
| N. oryzae | LC 6759 | Oryza sativa | China | KX986054 | KY019572 | - | - | |
| N. osmanthi | LC 4350 | Osmanthus sp. | China | KX986010 | MK263673 | - | - | |
| N. pyriformis | LC 4669 | Castanopsis sp. | China | KX986027 | KY019549 | - | - | |
| N. rubi | LC 2698 | Rubus sp. | China | KX985948 | KY019475 | - | KX986102 | |
| N. sphaerica | - | Tamarind (leaf) | Malaysia | MT043803 | MN719407 | - | - | |
| N. zimmermanii | CBS 167.26 | - | China | KY385308 | MT820147 | - | - | |
| SCBZSX5 | C. brevisporum | CBS 512.75 | Carica papaya | Australia | MG600761 | MG601029 | MG600966 | - |
| C. boninense | CBS 123755 | Schefflera heptaphylla | China | KM520014 | MK967343 | OM102984 | - | |
| C. cattleyicola | CBS 170.49 * | Cattleya sp. | Belgium | MG600758 | MG601026 | MG600963 | - | |
| C. cliviicola | CBS 125375 * | Clivia miniata | China | MG600733 | MG601000 | MG600939 | - | |
| C. cacao | CBS 119297 * | Theobroma cacao | Costa Rica | MG600772 | MG601039 | MG600976 | - | |
| C. panamense | CBS 125386 * | Merremia umbellata | Panama | MG600766 | MG601033 | MG600970 | - | |
| C. plurivorum | CBS 125474 | Abelmoschus esculentus | Japan | MG600727 | MG600990 | MG600933 | - | |
| C. excelsum—altitudinum | CGMCC 3.15130 * | Bletilla ochracea | China | HM751815 | JX625211 | KC843548 | - | |
| C. lobatum | IMI 79736 * | Piper catalpaefolium | Trinidad and Tobago | MG600768 | MG601035 | MG600972 | - | |
| C. orchidearum | CBS 135131 | Cymbidium hookerianum | China | HM585402 | MG601007 | MG600946 | - | |
| C. okinawense | CBS 143246 | Carica papaya | Japan | MG600767 | MG601034 | MG600971 | - | |
| C. sojae | CBS H 21495 | Glycine max | Iran | MG600755 | MG601022 | MG600960 | - | |
| C. dracaeneophilum | CBS 119360 | Dracaena sanderana | China | MG600711 | MG600978 | MG600918 | - | |
| C. tropicicola | CBS 133174 | Citrus sp. | Mexico | MG600716 | MG600983 | MG600923 | - | |
| SCBZSW6 | D. aeria | CGMCC 3.18353 | - | China | KY742205 | KY742293 | - | KY742051 |
| D. aquatica | CGMCC 3.18349 | - | China | KY742209 | KY742297 | - | KY742055 | |
| D. boeremae | CBS 109942 | Medicago littoralis | Australia | FJ426982 | FJ427097 | - | GU238048 | |
| D. chenopodii | CBS 128.93 | - | The Netherlands | GU237775 | GU237591 | - | GU238055 | |
| D. coffeae-arabicae | CBS 123380 | Coffea arabica | Ethiopia | FJ426993 | FJ427104 | - | GU238005 | |
| D. corylicola | CBS 146357 | Corylus avellana | Italy | MN954288 | MN958331 | - | MN954299 | |
| D. maydis | CBS 588.69 | Zea mays | USA | FJ427086 | FJ427190 | - | EU754192 | |
| D. nigricans | CBS 444.81 | - | The Netherlands | GU237867 | GU237558 | - | GU238000 | |
| D. sinensis | LC 8142 | - | China | KY742241 | KY742329 | - | KY742087 | |
| D. suiyangensis | LC 8144 | - | China | KY742244 | KY742332 | - | KY742332 | |
| D. maydis | CBS 588.69 | Zea mays | USA | FJ427086 | FJ427190 | - | EU754192 | |
| Item | Treatments | SCBZSL1 | SCBZSX5 | SCBZSW6 |
|---|---|---|---|---|
| Different light regimes (h) | 24 h/0 | - | 3.770 ± 0.028 a | - |
| 0 h/24 | - | 4.735 ± 0.064 b | - | |
| 12 h/12 | - | 4.250 ± 0.004 c | - | |
| Different pH | 5 | - | 5.156 ± 0.078 a | - |
| 7 | - | 4.305 ± 0.132 bc | - | |
| 9 | - | 4.054 ± 0.062 c | - | |
| 11 | - | - | - | |
| Different temperature (°C) | 5 | - | 4.074 ± 0.033 a | - |
| 10 | - | - | - | |
| 15 | - | 4.537 ± 0.052 b | - | |
| 20 | - | - | - | |
| 25 | - | 4.785 ± 0.022 c | - | |
| 30 | - | 4.650 ± 0.070 bc | - | |
| 35 | - | - | - | |
| Different media | PDA | - | 4.843 ± 0.064 a | - |
| C | - | - | - | |
| OA | - | - | - | |
| PSA | - | 4.081 ± 0.023 b | - | |
| MEA | - | - | - |
Disclaimer/Publisher’s Note: The statements, opinions and data contained in all publications are solely those of the individual author(s) and contributor(s) and not of MDPI and/or the editor(s). MDPI and/or the editor(s) disclaim responsibility for any injury to people or property resulting from any ideas, methods, instructions or products referred to in the content. |
© 2023 by the authors. Licensee MDPI, Basel, Switzerland. This article is an open access article distributed under the terms and conditions of the Creative Commons Attribution (CC BY) license (https://creativecommons.org/licenses/by/4.0/).
Share and Cite
Li, J.; Xu, J.; Wang, H.; Wu, C.; Zheng, J.; Zhang, C.; Han, Y. First Report of Fungal Pathogens Causing Leaf Spot on Sorghum–Sudangrass Hybrids and Their Interactions with Plants. Plants 2023, 12, 3091. https://doi.org/10.3390/plants12173091
Li J, Xu J, Wang H, Wu C, Zheng J, Zhang C, Han Y. First Report of Fungal Pathogens Causing Leaf Spot on Sorghum–Sudangrass Hybrids and Their Interactions with Plants. Plants. 2023; 12(17):3091. https://doi.org/10.3390/plants12173091
Chicago/Turabian StyleLi, Junying, Jingxuan Xu, Hongji Wang, Changfeng Wu, Jiaqi Zheng, Chaowen Zhang, and Yuzhu Han. 2023. "First Report of Fungal Pathogens Causing Leaf Spot on Sorghum–Sudangrass Hybrids and Their Interactions with Plants" Plants 12, no. 17: 3091. https://doi.org/10.3390/plants12173091
APA StyleLi, J., Xu, J., Wang, H., Wu, C., Zheng, J., Zhang, C., & Han, Y. (2023). First Report of Fungal Pathogens Causing Leaf Spot on Sorghum–Sudangrass Hybrids and Their Interactions with Plants. Plants, 12(17), 3091. https://doi.org/10.3390/plants12173091

